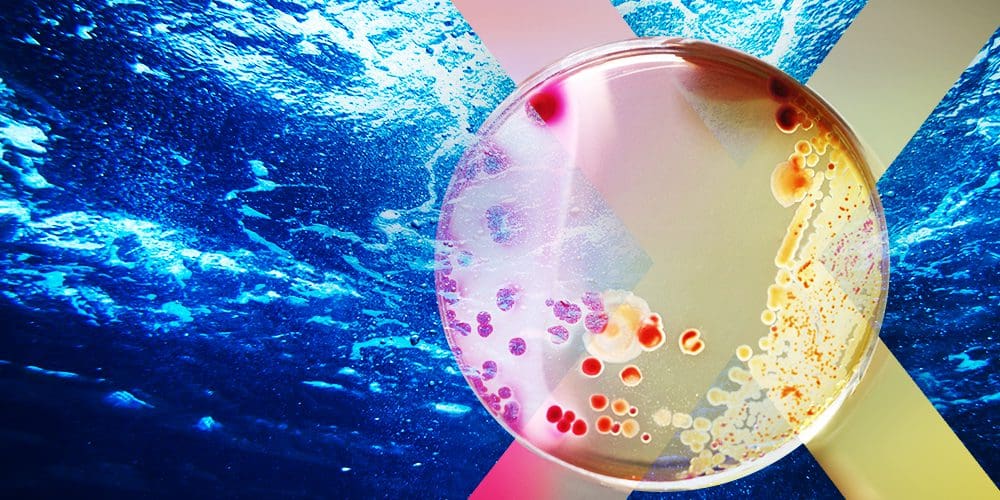
Drain brain: Meet the man who is fixing our wastewater problem

Drain brain: Meet the man who is fixing our wastewater problem
It’s getting harder and more energy intensive to treat our dirty water. In the latest episode of Solve for X, we talk to Patrick Kiely, CEO of Sentry Water Tech about the innovation that could make a huge difference.
Wastewater, the world’s dirty (not so little) secret, consumes nearly 3 percent of the global electricity demand. It’s a staggering statistic, and yet much of what actually happens with wastewater remains a mystery. Treatment plants typically purify water by infusing it with oxygen, creating an environment where bacteria can break down waste. But without proper sensors or data, the method is incredibly energy-intensive. Plus, with an influx of unregulated chemicals, our waste streams are becoming more toxic and harder to clean. In this episode of Solve for X, environmental microbiologist Patrick Kiely shares his unusual solution that harnesses the power of bacteria to help solve our wastewater problem. Unpleasant yet fascinating, Kiely’s work offers a glimpse into what it takes to clean our water and why it’s becoming the next big climate problem.
Featured in this episode:

Further reading:
- How tackling wastewater can help corporations achieve climate goals
- Phosphorus saved our way of life — and now threatens to end it
- “Water scarcity on a scale that we haven’t seen before” is coming
- The energy sector should care about wastewater
- Government of Canada backs innovative company pioneering new wastewater treatment technology
Subscribe to Solve for X: Innovations to Change the World here. And below find a transcript to the third episode: “Drain brain: Meet the man who is fixing our wastewater problem.”
Narration: Look, I have to warn you — in this episode, we’re going to be exploring a climate problem that is also kind of gross. Let’s just say it’s not something that you talk about around the water cooler at work.
Patrick: All of this stuff that you’re putting down the pipe, down your toilet — it goes somewhere. And unless you actively know how much you’re paying for that to be cleaned, unless you’re sure that it is being cleaned, you should probably go and start doing some digging.
Narration: Patrick Kiely is an environmental microbiologist. He founded a company called Sentry. He’s also an expert on wastewater treatment, how it gets clean and how much energy that takes.
Patrick: At the base level, it’s almost 3 percent of global electrical demand is going to wastewater treatment. So that’s a massive number in itself, and it’s certainly a silly number when you think: Oh we can reduce that by 30 percent, why haven’t we done that yesterday?
Narration: But it turns out it’s not that easy. Patrick is working to find a solution that could help lower how much energy is used. And he’s doing it in a kind of unusual way.
Patrick: So my background is understanding bacteria and how they grow in different environments.
Narration: When you think of bacteria, you might think of things you want to avoid like disease or infection. But they also play a vital role in breaking down waste. And paying closer attention to this invisible world might just help us deal with our wastewater problem.
I’m Manjula Selvarajah, and this is Solve for X: Innovations to Change the World, a series where we explore the latest ideas in tech and science. Most of the impacts we feel from climate change are in one way or another related to water — everything from flooding to droughts. And yet when you look at the money put toward climate finance, a fraction of that — just 3 percent — is directed toward water. That’s a massive disconnect. And it shows how unprepared we are to deal with the strain climate change is putting on our water system.
In this episode, we are going to be doing some digging to explore just how much energy it takes to clean our water. I reached out to Patrick Kiely in his office in Gatineau, to learn why treating wastewater is the next big climate problem.
Patrick Kiely: A wastewater treatment plant is one of the most complicated biological processes that you could imagine. You have to understand microbiology. You have to understand engineering, civil engineering, pumps, moving water, hydraulics. Like there’s just so much science that is around and culminates around wastewater processes. Most of what happens to wastewater, nobody knows about.
Manjula Selvarajah: I mean, my producer Ellie and I realized that we actually don’t know where our wastewater goes. When we flush our toilet, we don’t know where it goes. What happens when we flush our toilets?
Patrick Kiely: There’s what happens today, and the legacy maybe of 200 years of infrastructure development, and then there’s where it could go in the future. But at least today — so if you were sitting in Toronto — wastewater is going down a pipe into one location where it is treated. And basically what it contains is a series of massively large concrete basins — like the largest swimming pools you could possibly imagine — full of wastewater. And without anyone even realizing it, there’s someone at the other end with equipment that is trying to control that equipment, and he’s trying to bubble oxygen and air into wastewater tanks to match how much dirty water you’ve put down the drain.
Narration: Most treatment plants clean water by adding oxygen. That gives the bacteria what it needs to digest waste. But it’s actually a really energy intensive process and that translates to a big carbon footprint.
Patrick Kiely: You basically match or you align the amount of oxygen that you pump into the wastewater to how strong or how contaminated that wastewater stream is, and finding that balance is difficult, kind of impossible, today without better data and better sensors. That’s the first step. It’s just taking that really heavy, nasty — what we call carbon — but other people might call it poo.
Manjula Selvarajah: You said it! Go on.
Patrick Kiely: Yeah, I did. I did. I did — there’s lots of words we can get into. But now what we’re finding out, which is even crazier again, there’s all of these other things that we’re putting into our bodies that a lot of the time bacteria have never been exposed to them or designed to get rid of them.
Manjula Selvarajah: And plants may not be designed to get rid of them either.
Patrick Kiely: No, a lot of these, you know, endocrine disrupting compounds, contaminants of emerging concern, they’ve been designed specifically a lot of the time so that biomass doesn’t break them down. So the job of an operator has become incrementally more and more complex, the more and more we find out about what’s in our wastewater and how it impacts our environment. Because if you start flooding your ecosystem, your environment, with PFAS — which is the new one that people are beginning to find out — or painkillers, none of this stuff goes anywhere. It all goes into our ecosystem.
Manjula Selvarajah: And gets concentrated each time you go around the loop, right?
Patrick Kiely: Yeah, just builds up in these environments, gets more concentrated.
Manjula Selvarajah: It’s interesting, in preparing for this chat, we came across some pretty dire statistics. I’m going to share one with you and I’d like to have your help in making sense of it. So, 80 percent of wastewater in the world flows back into the ecosystem without being treated or reused. I found that a shocking stat. What do you make of that?
Patrick Kiely: I think you answered it almost for yourself at the beginning when we asked: well, where does your wastewater go? And nobody knows. So much about this is awareness. So if 80 percent of the world are not treating their wastewater, it’s a function of two things typically. A) They don’t have the resources or the capital to do that, or the infrastructure, and B) partially is, because they don’t know. They don’t know the impact these waste streams are having. And this has been the case forever, you know, even the city of Halifax. You don’t have to go too far to find locations where people still think it’s fine to have a big pipe that is just going into a large body of water and the concept of dilution is enough for people to be happy. But it’s not going far, and it’s certainly having an environmental impact.
Narration: Turns out Halifax didn’t have a plant to treat their water until 2008. The city of Victoria? They didn’t get theirs until just a few years ago. And even when you do have infrastructure, it can fail. Like in a storm, wastewater can go untreated and then end up in the environment. So our infrastructure is strained and climate change is making it even more complicated.
Manjula Selvarajah: Can you give me a sense of how much energy takes to treat wastewater?
Patrick Kiely: A typical town or a typical city in Canada, their energy bill — their total energy bill for the community, their municipal energy bill — about 25 percent of that goes to the wastewater treatment plant.
Manjula Selvarajah: That’s high. That’s a massive number.
Patrick Kiely: It’s a massive number. When you think about all the lights — everything that the town is doing — and then one quarter of everything they’re doing is just going to the wastewater treatment plant.
Narration: Canadians have the second highest water consumption in the world, and we generate close to 12.7 trillion liters of wastewater a day. That’s an awful lot of dirty water. But to reduce the amount of energy you use — without compromising safety — you need to have an idea of what’s actually in the water. And that’s the problem that Patrick is trying to crack. It’s an idea that came to him during his postdoc at Penn State.
Manjula Selvarajah: Take us back to the time that you were studying environmental microbiology. How did it lead to what you’re doing now?
Patrick Kiely: Okay, well, there’s a long version to that story and there’s a shorter version.
Manjula Selvarajah: We want the fun version — if there is a fun version.
Patrick Kiely: The fun version? So, I was doing a PhD in Ireland; I was researching how bacteria actually grow in people — immunocompromised people — this bacteria can get into their lungs. And after my PhD, I was reading a paper and it showed, that the bacteria I was working with, how that could be used to extract electrical energy from wastewater. And I was like: what are you on about? This is bananas. I’ve never heard of anything like this before. So there was a professor in Penn State University in the U.S. — he had just published this paper — so I sent him an email and I said, look, I’d love to do a postdoc in your lab. So yeah, I packed my bags, moved to the U. S., and we had a lab of maybe 15, 20 researchers from all over the world. And one day someone just opened a window and all of the reactors that we had running in the lab, the activity from these reactors — or the signals from it — all just dropped really fast. And that was that kind of lightning moment for myself where it was like: wow, we have an ability to monitor how all of these wastewater treatment systems are working just by understanding this level of biological activity.
Narration: That small change in temperature in the lab altered the behavior of bacteria. So Patrick realized that by paying attention to what the bacteria were doing, or not doing, he could help the treatment plant.
Patrick Kiely: And it was that kind of moment where something random happens and the penny drops and you just realize: Oh wow, all of these wastewater treatment systems — we can actually see how they’re performing with these types of surfaces and these types of special bacteria that we were cultivating in the laboratory. So in a sense, what we figured out was: Oh, we can actually see what’s happening now. Because up until then, nobody really knew how dirty the wastewater was. It was very much a black box type of environment, and that’s what the wastewater treatment industry has always been. And all of a sudden we had this new data, this new sensor information, coming directly from the bacteria.
Manjula Selvarajah: So in effect what the bacteria is doing is talking to you; you’re communicating with bacteria.
Patrick Kiely: In effect what we’ve developed is a Fitbit or a heart rate monitor for the bacteria. And when they have lots of food, they tell us, and they demonstrate that with lots of activity.
Manjula Selvarajah: So you have this data that — I mean, it seems like treatment plants know that what they have going out of their process is good water, but what they don’t have is the data on what’s coming in. And what you’re doing is, your sensors are providing data at that point at the front end?
Patrick Kiely: Yes, I mean your first statement there I would push back on it and I would just say firstly the regulations on water quality in Canada are nowhere near strong enough, and we need much better regulations on monitoring the quality of wastewater — treated wastewater — that’s actually going to our our watersheds. Because a lot of the time, a lot of wastewater treatment plants — a lot of treatment facilities — their regulation and the regulations only require them to sample that wastewater once a month sometimes, once a week sometimes, but very infrequently. So there is certainly a lack. And there’s also, by the way, bananas rules whereby you can bypass. So if it rains heavily in Canada for example, an operator can say, or the plant can say: Oh, you know what? Let’s just bypass all of this wastewater and put it directly into the…
Manjula Selvarajah: That we’re going to count on dilution?
Patrick Kiely: Yeah. Or just because I know it’s raining and I’m not going to be able to manage this flow of wastewater to my plant, I have a special rule that allows me just to send it directly into the lake or the river or stream.
Manjula Selvarajah: I had no idea.
Patrick Kiely: Yeah the regulations are very lax in Canada.
Manjula Selvarajah: So let’s talk about this data that you’re providing. What is the power that that kind of data gives the treatment plants? Like what changes can they make — can they or municipalities make — because they now have this data?
Patrick Kiely: The wastewater entering a wastewater treatment plant. The quality of that wastewater, the strength of the wastewater, it’s always changing and it’s changing because we’re human and we do things in patterns — i.e. we all go to the toilet basically at the same time and that’s reflected in the wastewater quality that enters a wastewater treatment plant. And we’ve been doing this for like four years now, just doing that monitoring aspect, and the insights that you begin to put out of it are so bananas and so interesting. Like even around COVID, when people stopped moving we saw shifts in the patterns, and when it rains heavily we see shifts in the patterns. But what we can do with that information now — because we have a real time measure of how concentrated the wastewater is going to the treatment plant — we can send a signal to the operator that says: okay, you’ve been adding oxygen all the time to meet the peak wastewater concentration coming into your plant. And that’s the way you’ve set it up because you haven’t had good data to know what the variation is or the variability is of that wastewater. So you’ve just been turning on all of your energy to that peak all day long. And that’s the right thing to do because without good data, you say: Well, I’m going to make sure it’s treated at the end. But the challenge is, it’s now 25 percent of your community’s electricity bill. And what we do is we can now provide that variable signal that shows the operator very clearly the pattern of when the high strength wastewater is coming in, when it’s a lot more dilute. We can provide them that information in real time and deliver that oxygen much more energy efficiently. In effect, it’s like having the heating system going in your house at 21 degrees Celsius all day long, 24 hours a day, 365 days a year. But maybe you’re only in the house for two hours a day.
Manjula Selvarajah: Is there a place, any country, that you can point to that is ahead on this issue? It doesn’t sound like Canada is from what I can — from all the hints that you’ve dropped.
Patrick Kiely: Canada is not horrific. But Canadians in general need to know that they’re not spending enough on water infrastructure.
Manjula Selvarajah: Who’s ahead then? If it’s not Canada, who’s ahead?
Patrick Kiely: The best country on the planet by a long way is Singapore.
Manjula Selvarajah: What is it that they’re doing?
Patrick Kiely: When you go to Singapore, on the news they’re talking about the water industry. Just the whole awareness of how valuable water is to people, is in front of people on a daily basis. So people understand water better and they understand how valuable it is. Also Singapore has a challenge because they need water. It’s like in Canada, we think: Oh, water is everywhere, we all have water. But that isn’t the case for most people on the planet. So when you need it, you value it more. In fact, what they call it — it’s water reuse facilities — they don’t use the word wastewater treatment plant. They’re called water reuse facilities. And that’s their goal is to make sure that it is a closed circle.
Manjula Selvarajah: So what they’re doing is … there’s that education, there’s the awareness, there’s even, sort of, the way that they’ve branded it. What about when it comes to technology?
Patrick Kiely: Once you put a value on something like that, and once you create a marketplace, then you go looking for solutions that allow you to do those things.
Manjula Selvarajah: Could you see wastewater being seen as a resource instead of a problem?
Patrick Kiely: That’s the holy grail. You know what, if I’m being optimistic, I would say yes …
Manjula Selvarajah: So what would that look like?
Patrick Kiely: … and then if I was being …
Manjula Selvarajah: Oh!
Patrick Kiely: …Well wait a second, wait a second! Because it depends what side of the bed I wake up in the morning and I realize: OK well, yes, that’s the way to do it and I should only be rosy and cheery. But the problem we’re having right now — because if wastewater just has let’s say, human waste, normal waste, normal things that we should be putting into our body … if it just has carbon, nitrogen, phosphorus — that is literally gold. Like, that on its own? The nitrogen and phosphorus are our best fertilizer. The carbon can be used in anaerobic digestion to generate renewable biogas. The problem is, what we’re now putting into our bodies, and what we’re putting into our wastewater, doesn’t just contain those things. And it contains these other chemicals that are not being regulated. Medications, people are taking them, people are just dumping stuff down the drain. You have manufacturers who are generating new chemicals all the time. They’re not being properly regulated on what they put on their side and that’s reaching the wastewater treatment plant. So the wastewater that we’re actually collecting today is not as good as it was or could be. And then it becomes something that is toxic. And then it’s: well, how do you actually deal with something that’s considered a toxic hazardous waste stream? You can’t use it as a fertilizer. Because a lot of people would have said: OK, the wastewater treatment plant of the future, we’re going to have anaerobic digestion, biogas — perfect. And we can still do that and that’s still definitely a massive low hanging fruit. But then what do you do with the waste from your digester? You have all of this accumulated — what we call — biosolids. So do you really want to give that to the farmer for him to then apply that onto your vegetables? Probably not. So the quality of what we put into our bodies is impacting the quality of what we can extract from these wastewater assets. And that’s the challenge.
Manjula Selvarajah: So the sense that I have through this conversation is that our existing infrastructure is inefficient. It has a large carbon footprint. But this infrastructure is already in place, it’s pricey. I mean, these are all barriers to change. What do you make of these barriers to change?
Patrick Kiely: Incentive drives everything. There’s no need to be building more tanks, there’s no need to be putting in any more piping. That exists. The easy, the low hanging fruit today — so I’ll give you a few numbers — about 70 to 75 percent of the energy demand at a wastewater treatment plant is just on the aeration, just on those blowers that are blowing air and oxygen into wastewater. That’s 70 percent, and you could almost half that. You can certainly reduce it by 30 percent by just putting better data at the front and optimizing how you add, or when you add, the oxygen. So if you could cut off a quarter of the electrical demand from your wastewater utility, just by doing a simple control like putting in a thermostat, that’s a massive step. So there are solutions. The question is: Who’s incentivized and how do we actually push those projects forward? And some of it’s communication. But you know, the operator of a typical wastewater treatment plant isn’t incentivized by saving energy. His salary doesn’t increase if he can reduce 5 percent off his energy bill. So you need to then communicate this value to other stakeholders within the community, and there needs to be pressure from other people within the community. Perhaps that’s local community groups, watershed groups. Other people need to be vocal about: no, no, no, we can do better here and help these operators. Because the operator always seems to be the one who’s at the end of the day, you know, oh my God, we’re discharging out of compliance. And the operator is like: Look at my infrastructure, what I’m having to deal with. So we need more money in the industry, more support for the operators, more people who are just eager to save energy and decarbonize.
Narration: It strikes me that part of the problem with solving this is that this is something we don’t like to talk about. I wondered whether we have the right words or tools.
Manjula Selvarajah: There are certain topics that I always think — even this conversation — I’ll tell you, I kept thinking: well, what are the words I should use? I went to Word Hippo and I looked up poop and I thought: well, let me see if I can find other words for it. There aren’t. And then I stopped and I said: but why am I looking for other words? Because I wanted to make the conversation palatable for our listeners. But why do I need to do that? Like why this weirdness around the word?
Patrick Kiely: In fact the more open we are, the better it is. Like understanding — I’ll do it — when you take a shit, it goes somewhere. And unless you’re paying for that to be cleaned, it’s going into your drinking water supply. That’s how important this is.
Manjula Selvarajah: Thank you Patrick for giving us the rosy, and not so rosy, view on that. I’m going to just take a break now. And I know Ellie’s probably jotted down a whole bunch of things that she wants to throw in. I’m just going to mute my mic so she can…
Ellen Payne Smith: We wanted to try one thing. Maybe we could do a small lightning round with some silly questions, and also more intelligent questions, just to see what your fast take on them would be?
Patrick Kiely: Love it.
Manjula Selvarajah: Okay, are you ready? You’ve got to be… [snaps fingers].
Patrick Kiely: You’re assuming that I’m going to answer in a fast manner… which is … but anyway.
Manjula Selvarajah: What do environmental microbiologists know that might surprise the general public?
Patrick Kiely: We know how clean or dirty the water is in your environment, and we know what’s causing the problems. And as an industry, we need to get better at communicating what’s causing those problems.
Manjula Selvarajah: What’s the worst thing you can put in the toilet or down the drain?
Patrick Kiely: Medication.
Manjula Selvarajah: How would you grade Canada’s wastewater treatment?
Patrick Kiely: The infrastructure? Like a 5 out of 10.
Manjula Selvarajah: Oh my goodness. OK, failing grade. Any jokes about your job that you’ve heard a thousand times?
Patrick Kiely: Poo doctor, I’m not a real scientist, poo doctor again. Yes, my kids like that, my wife loves to tell me that I’m a poo doctor.
Manjula Selvarajah: I love that. We’ll have to send you a shirt with that on at some point.
Solve for X is brought to you by MaRS. This episode was produced by Ellen Payne Smith. Lara Torvi and Heather O’Brien are the associate producers. David Paterson is the senior producer. Mack Swain composed the theme song and all the music in this episode. Gab Harpelle is our mix engineer. Kathryn Hayward is the executive producer. I’m your host Manjula Selvarajah. Watch your feed for new episodes coming soon.
MaRS helps entrepreneurs looking to scale solutions in climate tech, health and software. We offer targeted support through our Capital and Growth Acceleration programs. For more information, visit marsdd.com. And we want to hear from you — drop us a line to share your ideas, questions and feedback. Email us at media@marsdd.com.
Illustration by Workhouse
MaRS Staff
MaRS Staff